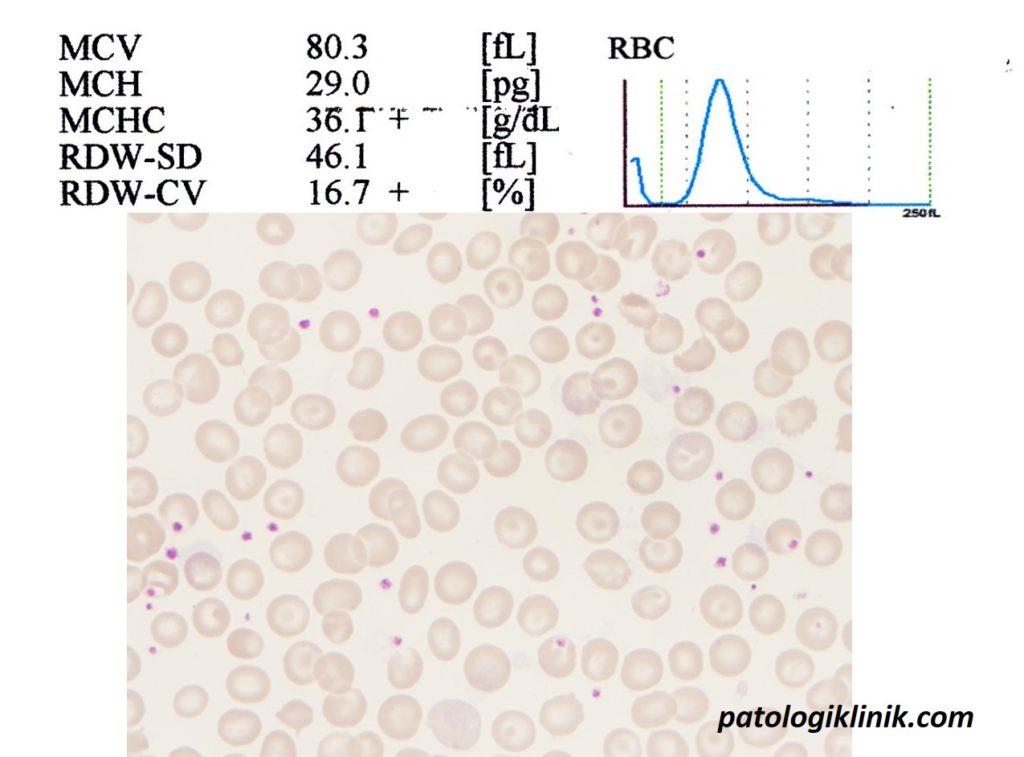

Memahami RDW-CV dan RDW-SD
Selain MCV dan MCH yang umum dikenal klinisi sebagai indeks eritrosit, alat darah lengkap (DL) otomatis juga menghasilkan parameter RDW (red cell distribution width) yang menunjukkan variasi ukuran eritrosit yang setara dengan derajat anisositosis pada pemeriksaan mikroskopis. Nilai RDW berasal dari pengukuran histogram eritrosit yang dinyatakan berupa RDW-SD (satuan fL) atau RDW-CV (%).

Nilai RDW-CV didapat dari rumus:

Pada praktiknya, RDW-CV lebih sering diinterpretasi dibandingkan RDW-SD, padahal RDW-CV ini sangat dipengaruhi oleh nilai MCV. Contohnya jika rentang 1SD lebar dengan nilai MCV rendah (eritrosit mikrositosis) maka akan terjadi peningkatan RDW-CV, sedangkan jika rentang 1SD lebar tetapi nilai MCV tinggi (eritrosit makrositosis) maka RDW-CV bisa hanya sedikit meningkat atau bahkan normal.
Berbeda dengan RDW-CV, RDW-SD diukur secara langsung dari lebar histogram pada tingkat frekuensi 20%. Partikel-partikel di bawah 20% biasanya merupakan artifak, aglutinat, rouleaux, agregat trombosit, dan giant trombosit. RDW-SD tidak dipengaruhi oleh MCV sehingga dianggap lebih baik dan reliabel dalam memperkirakan variasi ukuran eritrosit pada kondisi yang tidak abnormal atau 1SD yang sangat lebar.

Keuntungan RDW-CV dan RDW-SD
Penggunaan RDW-CV paling efektif pada distribusi eritrosit dalam rentang ±1 SD. Parameter ini merupakan indikator anisositosis yang baik pada nilai MCV dalam rentang rendah sampai normal dan jika anisositosis sulit dideteksi, contohnya pada kondisi defisiensi besi ringan. RDW-CV juga bermanfaat untuk memantau efek suplementasi besi dan transfusi darah dan untuk membedakan anemia defisiensi besi dengan thalassemia trait.
Sedangkan RDW-SD lebih baik digunakan pada distribusi eritrosit yang lebar, sampai di luar ±1 SD, yang dapat mencakup semua spektrum nilai MCV. Parameter ini lebih menggambarkan secara langsung morfologi eritrosit pasien dengan cara memperhatikan histogram eritrosit.

Dalam menginterpretasi RDW, selain memperhatikan RDW-CV dan RDW-SD, diharapkan juga memahami perbedaan populasi eritrosit yang homogen dan heterogen secara morfologis (apusan darah tepi), grafis (histogram), dan numeris (nilai RDW). Populasi eritrosit dianggap homogen jika morfologi secara mikroskopis memiliki ukuran yang sama, grafik histogram sempit, dan nilai RDW dalam rentang normal. Sedangkan populasi eritrosit heterogen ditunjukkan oleh morfologi ukuran eritrosit yang bervariasi, histogram lebar, dan nilai RDW meningkat.

Semoga bermanfaat.
Sumber:
- Caporal FA and Comar SR. Evaluation of RDW-CV, RDW-SD, and MATH-1SD for the detection of erythrocyte anisocytosis observed by optical microscopy. J. Bras. Patol. Med. Lab. 2013; vol.49 (5)
- Constantino BT. Red Cell Distribution Width, Revisited. Lab Medicine. 2013; Volume 44(2)
- Dacie and Lewis Practical Haematology 11th edition